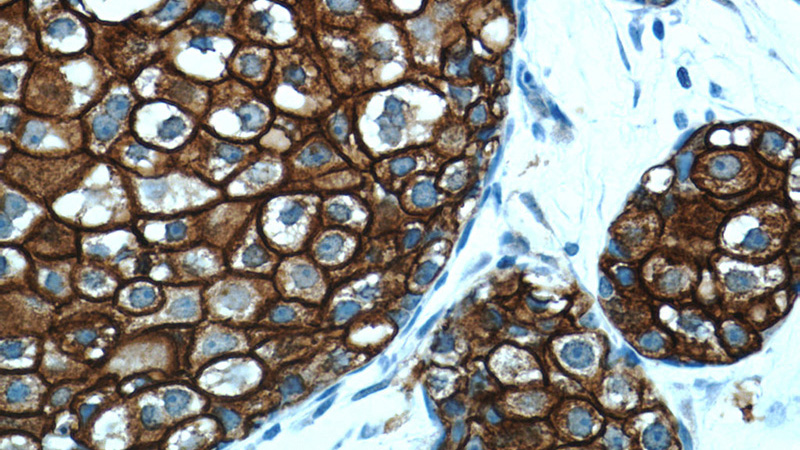
Immunohistochemistry of paraffin-embedded human breast cancer tissue slide using Catalog No:107260(ERBB2 Antibody) at dilution of 1:200 (under 40x lens)

-
Product Name
HER2/ErbB2 antibody
- Documents
-
Description
HER2/ErbB2 Mouse Monoclonal antibody. Positive IHC detected in human breast cancer tissue. Positive FC detected in HeLa cells.
-
Tested applications
ELISA, IHC, FC
-
Species reactivity
Human; other species not tested.
-
Alternative names
CD340 antibody; ERBB2 antibody; HER 2 antibody; HER 2/neu antibody; HER2 antibody; MLN 19 antibody; MLN19 antibody; NEU antibody; NGL antibody; p185 antibody; p185erbB2 antibody; Proto oncogene c ErbB 2 antibody; Proto oncogene Neu antibody; TKR1 antibody
-
Isotype
Mouse IgG2b
-
Preparation
This antibody was obtained by immunization of HER2/ErbB2 recombinant protein (Accession Number: NM_004448). Purification method: Protein A purified.
-
Clonality
Monoclonal
-
Formulation
PBS with 0.02% sodium azide and 50% glycerol pH 7.3.
-
Storage instructions
Store at -20℃. DO NOT ALIQUOT
-
Applications
Recommended Dilution:
IHC: 1:50-1:400
-
Validations

Immunohistochemistry of paraffin-embedded human breast cancer tissue slide using Catalog No:107260(ERBB2 Antibody) at dilution of 1:200 (under 10x lens)
Immunohistochemistry of paraffin-embedded human breast cancer tissue slide using Catalog No:107260(ERBB2 Antibody) at dilution of 1:200 (under 40x lens)

1X10^6 HeLa cells were stained with 0.2ug ERBB2 antibody (Catalog No:107260, red) and control antibody (blue). Fixed with 90% MeOH blocked with 3% BSA (30 min). Alexa Fluor 488-congugated AffiniPure Goat Anti-Mouse IgG(H+L) with dilution 1:1000.
-
Background
HER2, also known as ErbB2 and Neu, is a 185-kDa transmembrane glycoprotein that is a member of the epidermal growth factor (EGF) receptor family of receptor tyrosine kinases. It has no ligand binding domain of its own and therefore cannot bind growth factors. However, it does bind tightly to other ligand-bound EGF receptor family members to form a heterodimer, stabilizing ligand binding and enhancing kinase- mediated activation of downstream signalling pathways, such as those involving mitogen-activated protein kinase and phosphatidylinositol-3 kinase. Amplification and/or overexpression of HER2 have been reported in numerous cancers, including breast and ovarian tumors. HER2 is a therapeutic target for the treatment of breast cancer and other carcinomas.
Related Products / Services
Please note: All products are "FOR RESEARCH USE ONLY AND ARE NOT INTENDED FOR DIAGNOSTIC OR THERAPEUTIC USE"
